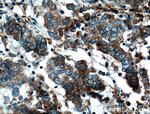
FKBP2 Antibody in Immunohistochemistry (Paraffin) (IHC (P))

Search
Proteintech
FKBP2 Monoclonal Antibody (2H7E8)
{{$productOrderCtrl.translations['antibody.pdp.commerceCard.promotion.promotions']}}
{{$productOrderCtrl.translations['antibody.pdp.commerceCard.promotion.viewpromo']}}
{{$productOrderCtrl.translations['antibody.pdp.commerceCard.promotion.promocode']}}: {{promo.promoCode}} {{promo.promoTitle}} {{promo.promoDescription}}. {{$productOrderCtrl.translations['antibody.pdp.commerceCard.promotion.learnmore']}}
产品信息
66091-1-IG
种属反应
宿主/亚型
分类
类型
克隆号
抗原
偶联物
形式
浓度
规格
纯化类型
保存液
内含物
保存条件
运输条件
产品详细信息
Immunogen sequence: MRLSWFRVL TVLSICLSAV ATATGAEGKR KLQIGVKKRV DHCPIKSRKG DVLHMHYTGK LEDGTEFDSS LPQNQPFVFS LGTGQVIKGW DQGLLGMCEG EKRKLVIPSE LGYGERGAPP KIPGGATLVF EVELLKIERR TEL (1-142 aa encoded by BC003384)
靶标信息
FKBP2 is a member of the immunophilin protein family, which play a role in immunoregulation and basic cellular processes involving protein folding and trafficking. This protein is a cis-trans prolyl isomerase that binds the immunosuppressants FK506 and rapamycin. It is thought to function as an ER chaperone and may also act as a component of membrane cytoskeletal scaffolds.
仅用于科研。不用于诊断过程。未经明确授权不得转售。
生物信息学
蛋白别名: 13 kDa FK506-binding protein; 13 kDa FKBP; epididymis secretory sperm binding protein; FK506 binding protein 2; FK506 binding protein 2, 13kDa; FK506-binding protein 2; FKBP-2; FKBP2; Immunophilin FKBP13; Peptidyl-prolyl cis-trans isomerase FKBP2; PPIase FKBP2; proline isomerase; rapamycin-binding protein; Rotamase
基因别名: FKBP-13; FKBP13; FKBP2; PPIase; RGD1560660
UniProt ID: (Human) P26885
Entrez Gene ID: (Human) 2286, (Pig) 100522180, (Rat) 293702